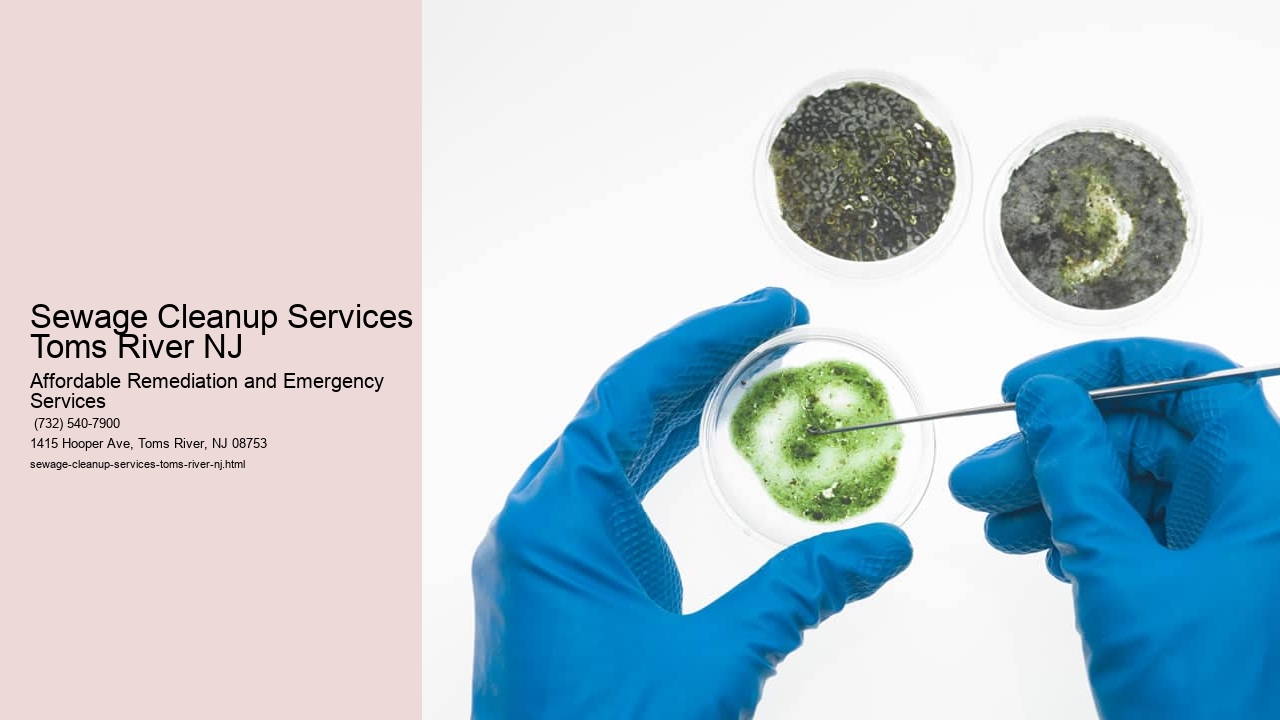

Operating since 2008, Affordable Remediation and Emergency Services is the leading provider of mold removal, mold remediation, and biohazard cleaning services in Toms River, NJ. Our licensed and trained certified experts offer 24/7 emergency biohazard cleanup and testing, ensuring thorough and safe handling of any crime scene, flood, or black mold cleaning.
Affordable Remediation and Emergency Services
1415 Hooper Ave, Toms River, NJ 08753, United States
(732) 540-7900
Mold is a pervasive issue that can infiltrate homes and businesses, leading to potential health risks and structural damage. In Toms River, NJ, where the climate can contribute to mold growth, the role of mold inspection companies becomes crucial for maintaining safe environments. These specialized firms are essential in detecting hidden mold infestations, preventing extensive property damage, and safeguarding residents' well-being.
Toms River's humid summers and stormy weather create ideal conditions for mold propagation. When left unchecked, mold spores rapidly multiply, contaminating air quality and surfaces within buildings. Mold exposure has been linked to various health problems such as respiratory issues, allergies, and even more severe complications for individuals with weakened immune systems.
Mold inspection companies possess the expertise to identify these insidious fungi through meticulous evaluation procedures. Unlike average homeowners who may overlook subtle signs of mold presence or misidentify harmless substances as harmful molds, professionals employ advanced techniques like infrared inspections and air sampling tests that accurately pinpoint affected areas.
Furthermore, by engaging a reputable mold inspection firm in Toms River early on when suspicion arises or after events like flooding or prolonged moisture exposure situations—residents can avoid costly remediations later on. Prompt identification allows for swift interventions that mitigate spread before it wreaks havoc on structures or jeopardizes occupants’ health.
In addition to immediate detection benefits, these companies offer valuable advice on preventative measures—such as proper ventilation strategies—to maintain an environment hostile to future mold outbreaks. They also educate clients on how different materials within their homes might affect susceptibility to mold issues; understanding which components like wood or drywall are more prone helps homeowners make informed decisions about maintenance practices.
The importance of engaging a professional service cannot be overstated when dealing with something as potentially hazardous as a mold infestation. A thorough inspection by qualified specialists not only reassures that living spaces remain healthy but also preserves the integrity of one’s investment into their property by staving off decay caused by unchecked fungal growth.
In summary, Toms River residents would do well to consider the critical services offered by local mold inspection companies designed to protect both their homes and health from unseen threats lurking behind walls or beneath floors. Through diligent surveillance paired with preventive education provided by these experts in mycology (the study of fungi), communities stand better guarded against stealthy microbial invaders eager to take hold wherever they find hospitable terrain.
View Home Mold Remediation Toms River NJ in a full screen map
| Entity | Definition |
|---|---|
| Mold Testing | Conducting tests to assess the presence and levels of mold in indoor environments. |
| Mold Removal | Removing mold growth from surfaces and materials to eliminate contamination. |
| Mold Remediation | Process of cleaning, sanitizing, and restoring areas affected by mold to prevent further spread. |
| Mold Prevention | Implementing measures to prevent mold growth and moisture buildup in a property. |
| Black Mold Cleanup | Specialized process of removing toxic black mold, also known as Stachybotrys, from indoor spaces. |
| Mold Inspection | Comprehensive assessment of a property to identify mold growth, moisture sources, and damage extent. |
| Mold Abatement | Permanent removal or encapsulation of mold-infested materials to prevent future growth and contamination. |
"Emergency Water Extraction in Toms River, NJ: What to Expect" offers an insightful look into the crucial service provided during unexpected water-related disasters. Whether due to natural calamities like hurricanes or mundane mishaps such as pipe bursts, residents of Toms River can find themselves suddenly battling against unwanted indoor floods.
At the heart of this emergency response is a highly specialized process designed not only for swift water removal but also for minimizing potential long-term damage to properties. The first step, upon calling professional extraction services, involves a prompt and thorough assessment of the affected area. This critical phase determines the extent of water intrusion and lays out a strategic plan tailored for effective remediation.
Equipped with cutting-edge technology, trained technicians arrive ready to tackle the inundation head-on. They utilize powerful pumps and vacuums that pull vast quantities of water from carpets, hardwood floors, and substructures with remarkable efficiency. This immediate action helps prevent further seepage and mitigates risks associated with mold growth and structural compromise.
Following extraction comes the drying stage where industrial-strength dehumidifiers and air movers are deployed throughout damp spaces. By circulating air expertly across wet surfaces, these machines facilitate speedy evaporation—a key factor in transforming soggy environments back to their pre-disaster states.
The journey towards full restoration doesn't end once visible water disappears; meticulous cleaning and sanitizing are paramount in ensuring health hazards do not linger post-flooding. Certified professionals engage in rigorous procedures that aim to eradicate contaminants brought by floodwaters, guaranteeing a safe return for residents to their cherished homes.
In conclusion, when faced with an aquatic upheaval in Toms River, NJ, understanding what encompasses emergency water extraction can provide peace of mind amidst chaos. With competent experts at hand around-the-clock preparedness meets resilience—allowing communities to bounce back stronger after being tested by nature's unpredictability.

We serve a wide range of areas in New Jersey including Toms River, Ocean County, Wall Township, Freehold, Lacey Township, Ocean Township, Middlesex, Monmouth County, Jackson Township, Barnegat Township, Farmingdale, and Manchester Township.
We prioritize customer satisfaction by providing honest, reliable, and efficient services backed by our experienced professionals and industry-leading techniques.
Affordable Remediation and Emergency Services offers a comprehensive range of services including mold testing, sewage cleanup, water damage restoration, water mitigation, mold removal, and water extraction.
Yes, in addition to mold removal, we also provide services such as sewage cleanup, water damage restoration, water mitigation, and water extraction to address various emergency situations. |
If you suspect mold growth in your property, it's crucial to contact us immediately for a thorough inspection and prompt remediation to prevent further damage and health risks.